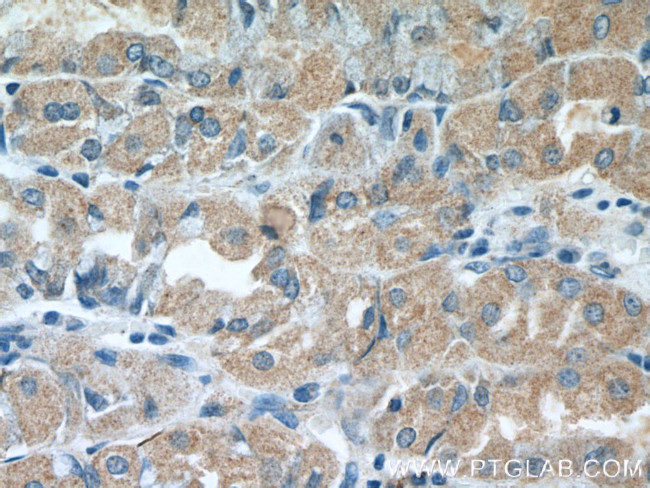
ST14 Antibody in Immunohistochemistry (Paraffin) (IHC (P))

Search
Proteintech
ST14 Polyclonal Antibody
{{$productOrderCtrl.translations['antibody.pdp.commerceCard.promotion.promotions']}}
{{$productOrderCtrl.translations['antibody.pdp.commerceCard.promotion.viewpromo']}}
{{$productOrderCtrl.translations['antibody.pdp.commerceCard.promotion.promocode']}}: {{promo.promoCode}} {{promo.promoTitle}} {{promo.promoDescription}}. {{$productOrderCtrl.translations['antibody.pdp.commerceCard.promotion.learnmore']}}
产品信息
27176-1-AP
种属反应
宿主/亚型
分类
类型
抗原
偶联物
形式
浓度
规格
纯化类型
保存液
内含物
保存条件
运输条件
产品详细信息
Immunogen sequence: YNLTFHSSQ NVLLITLITN TERRHPGFEA TFFQLPRMSS CGGRLRKAQG TFNSPYYPGH YPPNIDCTWN IEVPNNQHVK VRFKFFYLLE PGVPAGTCPK DYVEINGEKY CGERSQFVVT SNSNKITVRF HSDQSYTDTG FLAEYLSYDS SDPCPGQFTC RTGRCIRKEL RCDGWADCTD HSDELNCSCD AGHQFTCKNK FCKPLFWVCD SVNDCGDNSD EQGCSCPAQT FRCSNGKCLS (301-539 aa encoded by BC030532)
靶标信息
SOX2 is an intronless gene encoding a member of the SRY-related HMG-box (SOX) family of transcription factors involved in the regulation of embryonic development and in the determination of cell fate. The product of the SOX2 gene is required for stem-cell maintenance in the central nervous system, and also regulates gene expression in the stomach. The SOX2 gene lies within an intron of another gene called SOX2 overlapping transcript (SOX2OT). Further, SOX2 protein may act as a transcriptional activator after forming a protein complex with other proteins. Mutations in the SOX2 gene have been associated with bilateral anophthalmia, a severe form of structural eye malformation, optic nerve hypoplasia and syndromic microphthalmia.
仅用于科研。不用于诊断过程。未经明确授权不得转售。
篇参考文献 (0)
生物信息学
蛋白别名: associated with human ovarian cancer; channel-activating protein 3; Matriptase; Membrane-type serine protease 1; MT-SP1; MT-SP1; chymotrypsin clan serine protease; MTSP-1; Prostamin; Serine protease 14; Serine protease TADG-15; serine protease with trypsin-like activity; suppression of tumorigenicity 14 (colon carcinoma); suppression of tumorigenicity 14 (colon carcinoma, matriptase, epithin); Suppressor of tumorigenicity 14 protein; TADG-15; tumor associated differentially expressed gene 15 protein; Tumor-associated differentially-expressed gene 15 protein; unnamed protein product
基因别名: ARCI11; CAP3; HAI; MT-SP1; MTSP1; PRSS14; SNC19; ST14; TADG15; TMPRSS14
UniProt ID: (Human) Q9Y5Y6
Entrez Gene ID: (Human) 6768